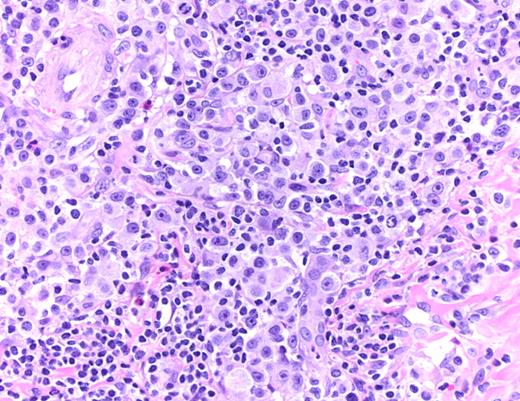
Figure 3. LYP: Large pleomorphic and anaplastic tumor cells intermingled with small lymphocytes, eosinophils, and histiocytes (hematoxylin and eosin, original magnification ×200). Histologic photomicrograph was captured using a digital camera (AxioCam MRc5; Zeiss) mounted on an Olympus microscope (BX45; Olympus). Objective lens: 400×/0.75 NA. Imaging software: Axio Vision Release 4.8.2 (Zeiss) and Adobe Photoshop Version 8.0 (Adobe Systems).
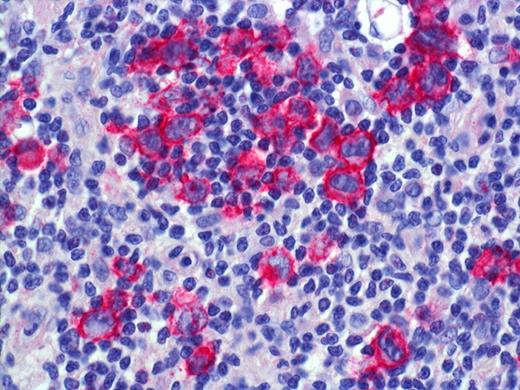
Figure 4. LYP: Expression of CD30 by scattered and clustered pleomorphic tumor cells. Histologic photomicrograph was captured using a digital camera (AxioCam MRc5; Zeiss) mounted on an Olympus microscope (BX45; Olympus). Objective lens: 400×/0.75 NA. Imaging software: Axio Vision Release 4.8.2 (Zeiss) and Adobe Photoshop Version 8.0 (Adobe Systems).
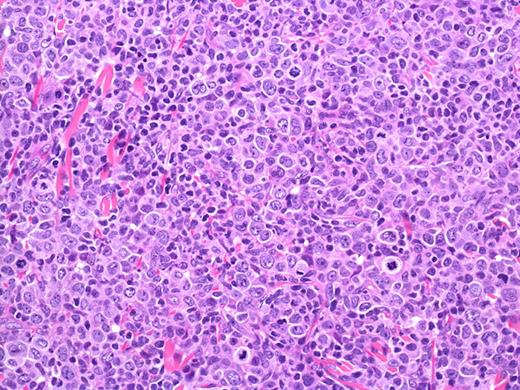
Figure 5. PCALCL: Cohesive sheets of anaplastic lymphoid cells H&E, original magnification ×200). The histologic photomicrograph was captured using a digital camera (AxioCam MRc5; Zeiss) mounted on an Olympus microscope (BX45; Olympus). Objective lens: 400×/0.75 NA. Imaging software: Axio Vision Release 4.8.2 (Zeiss) and Adobe Photoshop Version 8.0 (Adobe Systems Inc).

Abstract
Primary cutaneous CD30+ lymphoproliferative disorders (CD30+ LPDs) are the second most common form of cutaneous T-cell lymphomas and include lymphomatoid papulosis and primary cutaneous anaplastic large-cell lymphoma. Despite the anaplastic cytomorphology of tumor cells that suggest an aggressive course, CD30+ LPDs are characterized by an excellent prognosis. Although a broad spectrum of therapeutic strategies has been reported, these have been limited mostly to small retrospective cohort series or case reports, and only very few prospective controlled or multicenter studies have been performed, which results in a low level of evidence for most therapies. The response rates to treatment, recurrence rates, and outcome have not been analyzed in a systematic review. Moreover, international guidelines for staging and treatment of CD30+ LPDs have not yet been presented. Based on a literature analysis and discussions, recommendations were elaborated by a multidisciplinary expert panel of the Cutaneous Lymphoma Task Force of the European Organization for Research and Treatment of Cancer, the International Society for Cutaneous Lymphomas, and the United States Cutaneous Lymphoma Consortium. The recommendations represent the state-of-the-art management of CD30+ LPDs and include definitions for clinical endpoints as well as response criteria for future clinical trials in CD30+ LPDs.
Introduction
Primary cutaneous CD30+ lymphoproliferative disorders (CD30+ LPDs) are the second most common form of cutaneous T-cell lymphomas (CTCLs) and represent a spectrum of diseases, including lymphomatoid papulosis (LYP) and primary cutaneous anaplastic large-cell lymphoma (PCALCL).1-3 LYP and PCALCL share the expression of CD30 antigen as a common immunophenotypic hallmark and exhibit an excellent prognosis but differ in regard to their clinical presentation. LYP is characterized by a chronic course of years to decades of recurrent papulonodular lesions (Figure 1), each of which undergoes spontaneous regression after weeks or months. Survival is unaffected, but patients with LYP are at risk for second cutaneous or nodal lymphoid malignancies, including mycosis fungoides (MF), cutaneous or nodal anaplastic large-cell lymphoma (ALCL), and Hodgkin lymphoma. These LYP-associated lymphomas, which are clonally related in some cases, develop in 4%-25% of affected patients and may occur before, concurrent with, or after the onset of LYP.4,5
LYP: Grouped papules in the knee region. Note scars and hyperpigmentation as residual changes after spontaneous regression of the lesions. Clinical image was captured using a digital camera (Nikon Coolpix 995; Nikon).
LYP: Grouped papules in the knee region. Note scars and hyperpigmentation as residual changes after spontaneous regression of the lesions. Clinical image was captured using a digital camera (Nikon Coolpix 995; Nikon).
PCALCL manifests in most patients with a solitary or grouped, rapidly growing and ulcerating large tumors or thick plaques (Figure 2). Rarely, the disease manifests with multifocal lesions. Spontaneous complete or partial regression of the tumor(s) is reported in up to 44% of the patients.4,6 In contrast to its nodal counterpart, PCALCL has a favorable prognosis with 5-year survival rates between 76% and 96%.7 Based on the data of one study on a limited number of patients, involvement of locoregional lymph nodes is not associated with a worse prognosis than cutaneous involvement alone.4 Skin-limited relapses are found in 39% of patients and extracutaneous spread in 13% of the patients.8
PCALCL: Solitary ulcerated nodule on the leg. Clinical image was captured using a digital camera (Nikon Coolpix 995; Nikon).
PCALCL: Solitary ulcerated nodule on the leg. Clinical image was captured using a digital camera (Nikon Coolpix 995; Nikon).
A broad variety of therapeutic approaches have been reported for CD30+ LPDs. UV light phototherapy and low-dose methotrexate (MTX) are commonly used therapies for LYP, but relapses are common and sustained CRs are rarely achieved.9 In PCALCL, surgical excision and radiotherapy are most commonly used for solitary tumors, whereas chemotherapy is given for multifocal disease. The histologic findings of both LYP and PCALCL with large pleomorphic and anaplastic lymphoid tumor cells and the clinical appearance with rapidly growing or multiple lesions may result in misinterpretation as a highly malignant cutaneous or even systemic T-cell non-Hodgkin lymphoma, leading to recommendations for multiagent chemotherapy or even bone marrow transplantation.10,11 In addition, the increased incidence of second lymphoid neoplasms in LYP patients has been used as support for early and more intense treatment of LYP.12,13
Although a broad spectrum of therapy regimens has been reported, these have been limited to small cohort series or case reports. Indeed, there are little data from prospective controlled or multicenter studies in CD30+ LPDs. Furthermore, the response rate to treatment, recurrence rate, and outcome have not been analyzed in a systematic review. Recommendations for the treatment of CD30+ LPDs previously have been published,4,5,14 but international guidelines for the treatment of CD30+ LPDs have not yet been established. This article reviews the therapeutic regimens reported in the literature by focusing on response rates to initial treatment, recurrence rates, and follow-up. Recommendations for the management of CD30+ LPDs are presented based on these data and the expertise of the members of the European Organization for Research and Treatment of Cancer (EORTC), the International Society for Cutaneous Lymphomas (ISCL), and the United States Cutaneous Lymphoma Consortium (USCLC).
Development process of recommendations
To identify relevant reports on the treatment of CD30+ LPDs, a search in Pub Med was performed using the following terms: lymphomatoid papulosis, cutaneous lymphoma, large-cell, anaplastic, CD30, treatment, and therapy. References were selected that reported detailed data on the initial treatment, response to treatment, relapse rates, and outcome. Case reports and retrospective case series describing treatment results with follow-up and response, and results from uncontrolled and controlled interventional studies published until April 2011 were included because the number of prospective studies in CD30+ LPDs is very small. Articles with only general statements, which did not allow extraction of detailed data, review articles merely reporting previous literature, and meeting abstracts were excluded. Because the data of some patients have been included in multiple reports (R.W., personal oral communication), the exact number of patients could not be determined with certainty. Documentation of response to treatment was often not reported according to current oncology standards. Instead of defined endpoints, several studies described the responses in general terms, such as “good clinical effect,” “improvement of skin lesions,” or “alive and well.”
The included articles were stratified for the level of evidence according to the Oxford Center for Evidence-based Medicine (www.cebm.net). Only cases with unequivocal diagnosis of LYP or PCALCL according to the defining criteria (Table 1) were included in further analysis. Patients presenting with nodal or other extracutaneous involvement at diagnosis or staging, secondary cutaneous ALCL, and immunosuppression-associated forms of CD30+ LPDs were excluded.
Based on these data and the previously published recommendations by national expert groups,4 a proposal for the recommendations was presented to the EORTC Cutaneous Lymphoma Task Force, the Board of Directors of the ISCL, and the USCLC and modified based on modifications by these members of the societies.
Diagnosis and staging of CD30+ LPDs
Diagnostic procedure
The diagnostic criteria for CD30+ LPDs are outlined in Table 1. Histologic examination is the first diagnostic step in the diagnostic workup of clinically suspected CD30+ LPDs. As for other forms of cutaneous lymphomas, either complete excision (eg, a papule or small nodule in LYP) or an incisional biopsy (spindle-shaped biopsy of adequate length and depth or a punch biopsy of at least 4 mm) is recommended to allow appropriate histologic workup.
The histologic features of LYP are variable and depend on the evolution of the lesions. Four histologic subtypes (A-D) have been delineated, which represent a spectrum with overlapping features and may be present in individual patients at the same time15,16 (Table 1). Immunohistochemistry plays a pivotal role by revealing the presence of CD30+ large pleomorphic or anaplastic T cells. By definition, CD30 is expressed by at least 75% of the tumor cells in PCALCL.1-3 Differentiation of LYP and PCALCL from other forms of CTCL and secondary cutaneous involvement by nodal Hodgkin lymphoma or systemic ALCL requires careful clinicopathologic correlation.17,18
LYP: Large pleomorphic and anaplastic tumor cells intermingled with small lymphocytes, eosinophils, and histiocytes (hematoxylin and eosin, original magnification ×200). Histologic photomicrograph was captured using a digital camera (AxioCam MRc5; Zeiss) mounted on an Olympus microscope (BX45; Olympus). Objective lens: 400×/0.75 NA. Imaging software: Axio Vision Release 4.8.2 (Zeiss) and Adobe Photoshop Version 8.0 (Adobe Systems).
LYP: Large pleomorphic and anaplastic tumor cells intermingled with small lymphocytes, eosinophils, and histiocytes (hematoxylin and eosin, original magnification ×200). Histologic photomicrograph was captured using a digital camera (AxioCam MRc5; Zeiss) mounted on an Olympus microscope (BX45; Olympus). Objective lens: 400×/0.75 NA. Imaging software: Axio Vision Release 4.8.2 (Zeiss) and Adobe Photoshop Version 8.0 (Adobe Systems).
Staging
Staging should begin with a complete history, including previous lymphoid neoplasms (in particular Hodgkin lymphoma and MF),B-symptoms, and a careful physical examination (Table 2). Patients with suspected LYP should be asked for waxing and waning of recurrent papulonodular lesions within weeks. Recommended laboratory studies include a complete blood cell count with differential, blood chemistry, and lactate dehydrogenase. In LYP patients with the typical manifestation of papulonodular skin lesions and spontaneous regression of individual lesions after a few weeks and nothing on physical examination or blood tests to suggest extracutaneous disease, there is no need for the radiologic staging examination or bone marrow biopsy. However, where physical examination or laboratory tests are suggestive of extracutaneous disease in LYP, lymph node sonography, chest x-ray, CT, or positron emission tomography/CT scan should be performed. In patients with PCALCL, adequate imaging studies (contrast-enhanced CT scan with or without positron emission tomography, or whole body integrated positron emission tomography) should be performed. In both LYP and ALCL, a lymph node biopsy should be performed if a suggestion of nodal lymphoma exists. Recent data indicate that bone marrow examination has limited value in the staging of patients with an ALCL first presenting in the skin and may therefore be reserved for selected cases with multifocal tumors, unexplained abnormal hematologic results, and those in whom extracutaneous disease is documented.19
LYP: Expression of CD30 by scattered and clustered pleomorphic tumor cells. Histologic photomicrograph was captured using a digital camera (AxioCam MRc5; Zeiss) mounted on an Olympus microscope (BX45; Olympus). Objective lens: 400×/0.75 NA. Imaging software: Axio Vision Release 4.8.2 (Zeiss) and Adobe Photoshop Version 8.0 (Adobe Systems).
LYP: Expression of CD30 by scattered and clustered pleomorphic tumor cells. Histologic photomicrograph was captured using a digital camera (AxioCam MRc5; Zeiss) mounted on an Olympus microscope (BX45; Olympus). Objective lens: 400×/0.75 NA. Imaging software: Axio Vision Release 4.8.2 (Zeiss) and Adobe Photoshop Version 8.0 (Adobe Systems).
PCALCL: Cohesive sheets of anaplastic lymphoid cells H&E, original magnification ×200). The histologic photomicrograph was captured using a digital camera (AxioCam MRc5; Zeiss) mounted on an Olympus microscope (BX45; Olympus). Objective lens: 400×/0.75 NA. Imaging software: Axio Vision Release 4.8.2 (Zeiss) and Adobe Photoshop Version 8.0 (Adobe Systems Inc).
PCALCL: Cohesive sheets of anaplastic lymphoid cells H&E, original magnification ×200). The histologic photomicrograph was captured using a digital camera (AxioCam MRc5; Zeiss) mounted on an Olympus microscope (BX45; Olympus). Objective lens: 400×/0.75 NA. Imaging software: Axio Vision Release 4.8.2 (Zeiss) and Adobe Photoshop Version 8.0 (Adobe Systems Inc).
Staging according to the Ann Arbor staging system or TNM staging system categorizes patients with nonregional LYP and patients with multifocal PCALCL as stage IV, which would imply advanced disease and unfavorable prognosis. The prognosis of both LYP and PCALCL, including its multifocal forms, is excellent so that these staging systems do not reflect the biology of the diseases. We therefore recommend documentation of CD30+ LPDs according to the recently published ISCL/EORTC recommendations for staging of cutaneous lymphomas other than MF/Sézary syndrome.20
Therapy results
For PCALCL, 52 of 161 references were selected for further analysis. These references included 23 case reports (44%), 23 (retrospective) cohort series (44%), and 6 prospective therapeutic trials (12%), including a total of 368 patients. For LYP, 207 references matching the search terms were retrieved. Sixty-two reports were selected for further analysis. These included 27 case reports (44%), 30 (retrospective) cohort series (48%), and 5 prospective therapeutic trials (8%). Because the majority of reported data are from case reports and retrospective cohort series, evidence was scored as level 4 or 5 for the majority of the reports and grades of recommendation were primarily of the C or D category.
The data of larger cohort studies, which each included > 30 patients, did not allow conclusions to be drawn on the effect of the chosen therapies because response and relapse rates as well as follow-up data were not separated with regard to the therapeutic modalities. Patients with LYP and patients with relapsing PCALCL often have been treated with various therapies subsequently or concurrently, making it impossible to determine which of the therapeutic interventions was the most effective in inducing partial or CR.
Therapy of PCALCL results
Surgical excision (SE) and radiotherapy (RT) are the most common and best documented therapies for solitary or localized PCALCL. Chemotherapeutic approaches have been used mainly in patients with multifocal or relapsing disease. The number of patients per therapeutic modality and the response and relapse rates for the best documented and most widely used therapies are given in Table 3. Anecdotal reports with only 1 or 2 patients and reports on other therapies, for which mostly < 10 patients were reported, are listed in Table 4. Because of the small number of patients, these data did not allow conclusions to be drawn on the efficacy of treatment.
Surgical excision
SE alone as initial therapy was the most common approach and was used in 19%-57% of the patients.4,8,21-28 Fifty-three patients treated with SE alone could be further analyzed. Because SE was performed with the intention to remove the entire tumor, no response rates were provided, except for 2 studies reporting complete remission (CR) as initial response to SE in all of 27 patients.8,23 No information was given regarding the margins of excision. Relapses occurred in 19 of 44 patients (43%).8,21-23,25,27,28 Most reports do not state whether the relapses occurred at the treated site or at other sites. Two or more relapses limited to the skin were found in 7 of 11 patients.23 Delay to first relapse ranged from 2-76 months.23,27,28 Seventy-eight percent (32 of 41) of the patients were alive without disease after a median follow-up of 39 months (range, 4-109 months).22-25,27,29
RT
RT was applied as first-line monotherapy for PCALCL in up to 48% of the patients.4,22,23,25,26 The radiation dose ranged from 30-46 Gy with a median diameter of the lesional region of 3 cm and a 2- to 3-cm margin of uninvolved perilesional skin.30 RT with a dose of 40 Gy in 2-Gy fractions was reported to be well tolerated with only mild and transient side effects.30 The only recorded toxicity was radiation dermatitis grade 1 to 2 seen in all patients.30 CR occurred in 19 of 20 patients (95%) for whom detailed data on response were reported.8,22,30-35 Recurrences were observed in 9 of 22 patients (41%) after a median follow-up period of 22 months (range, 5-95 months).8,22,23,25,32,34,35 One study reported a disease-free duration to first relapse of 14 months (range, 2-59 months) in 4 patients with skin-limited relapses.23 Data of 11 patients with PCALCL treated with SE followed by RT could be analyzed21,23,25,36 with a sustained CR in 4 of 6 patients (67%), for whom response rates were available. The recurrence rate after treatment with SE and RT was 64% (7 of 11 patients) with a disease-free period to first relapse of 34 months (range, 8-54 months).21,23,25,36
Chemotherapy
Fifty-three patients, for whom detailed data had been documented, were treated with multiagent chemotherapy. CR rate to multiagent chemotherapy was 92% (36 of 39 patients). Relapses were reported in 16 of 26 patients (62%). Disease-free time to relapse, which was only reported for 4 patients, was 4 months (median; range, 1-12 months).27,37-39 Doxorubicin-based multiagent chemotherapy with cyclophosphamide, doxorubicin, vincristine, and prednisone (CHOP) was applied as initial therapy was separately analyzed. CHOP resulted in CR in 11 of 13 patients (85%) and relapses in 5 of 7 patients (71%).8,28,37,39-43 The median duration of remission was only 6 weeks (range, 4-8 weeks; 3 patients).
Multiagent chemotherapy has been considered as first-line therapy for multifocal PCALCL. Eight of 10 patients (80%) with multifocal PCALCL treated with multiagent chemotherapy (various regimens) had relapses in the skin and/or involvement of lymph nodes.22,24-26,40,44,45 There are only limited data on treatment of extracutaneous spread in PCALCL. Chou et al reported 2 patients with PCALCL and subsequent involvement of lymph nodes who were in CR after CHOP and radiation therapy, but relapses occurred in both patients after a few months.31
Monoclonal antibodies
SGN-30, a chimeric monoclonal antibody to CD30, has been used in 13 patients with PCALCL.40,47,48 In an open-label multicenter phase 2 study, 6 of 11 (55%) patients achieved CR and 3 of 11 (27%) patients showed partial remission (PR).48 No disease progression was observed. The treatment was well tolerated. Brentuximab vedotin (SGN-35) is the same monoclonal antibody linked to the antitubulin agent monomethyl auristatin E, which enhances the antitumoral activity of CD30-directed therapy. In a phase 1 study, brentuximab vedotin induced durable responses and resulted in tumor regression in most patients with relapsed or refractory CD30-positive lymphomas.49
Other treatments
Recommendations
Treatment of PCALCL should be tailored to the size and extent of tumors (Table 5). For solitary or grouped lesions, SE or RT is recommended as initial or first-line therapy. Both therapeutic approaches achieve a CR of at least 95%. Relapses after SE or RT occur in ∼ 40% of patients and are equally frequent after both interventions. Relapses confined to the skin are not linked to worsened prognosis and do not require different treatment than initial tumors. Spontaneous regression of tumors has been observed in up to 44% of the PCALCL patients, most of them presenting with solitary or localized lesions, but also in patients with multifocal disease.4,6,8,23,25,56,57 Onset of spontaneous tumor regression took place after a median period of 2 months (range, 1 week to 6 months). Patients should be informed that outcome after spontaneous regression of initial or recurrent tumors is excellent. It remains to be clarified whether patients with extensive limb disease should be treated in a different way than PCALCL at other localizations because recent studies reported worse prognosis for patients with extensive limb disease and PCALCL located on the leg.7,58
Multiagent chemotherapy has often been used as first-line therapy especially in multifocal PCALCL. CR rate to multiagent chemotherapy as initial therapy was 92% overall and 85% specifically for CHOP, which is the most common type of multiagent chemotherapy in malignant lymphomas. Relapses are very common and seen in 62% of all PCALCL patients treated with chemotherapy and in 71% of the patients initially treated with CHOP. No specific chemotherapeutic protocol has so far been shown to be superior. Thus multiagent chemotherapy and, in particular, CHOP can no longer be recommended as first-line therapy for multifocal or relapsing PCALCL limited to the skin.4,31 As alternative therapy, low-dose MTX (5-25 mg/week), which is generally not myelosuppressive, has been proposed as first-line therapy for multifocal PCALCL.4,31 Despite MTX having been proven to be effective in clearing LYP lesions, the reported experience in multifocal PCALCL is very limited and evidence is lacking for MTX in multifocal PCALCL despite a general expert consensus that its use is reasonable.4,38 Systemic retinoids, including bexarotene, IFN-α, and thalidomide, have been described in anecdotal reports as effective treatment for multifocal PCALCL not responsive to other therapies. Maintenance therapy over months to years seems to be necessary with this immunomodulatory therapy.50,55 Multiagent chemotherapy is only indicated for extracutaneous spread.
Lymphomatoid papulosis therapy
Topical steroids, photochemotherapy (psoralen-UVA light therapy [PUVA]), and low-dose MTX are the best documented and most common therapeutic approaches for LYP reported in the literature. The number of patients per therapeutic modality and the response rate to these therapies are given in Table 6. Anecdotal reports with only 1 or 2 patients and reports on other therapies, for which mostly < 10 patients were reported, are listed in Table 7.
Phototherapy
Even though phototherapy is one of the most common therapies in LYP, most reports do not provide details on the dosage or lack prolonged follow-up, making it difficult to draw conclusions on its effectiveness. Remarkably, there is no prospective study evaluating any form of phototherapy in LYP. Detailed data on response were available for 19 patients treated with PUVA or bath-PUVA. Thirteen of 19 patients (68%) experienced PR and 5 patients (26%) CR.59-68 Relapses were observed in all patients shortly after cessation of treatment, except for 3 patients (16 of 19 patients; 84%). UVB light therapy was effective in 6 of 7 children.69 UVA1 in a cumulative dose of 600-1800 J/cm2 induced CR in 5 of 9 patients (56%) and PR with reduction of more than 50% of the lesions in the remaining 4 patients. Three of 7 patients, for whom follow-up was available, showed relapse after 1 to 20 months at follow-up.70 Heliotherapy or exposure to sunlight was reported to be beneficial in 21 of 37 (57%) children.69,71,72 In summary, most patients with LYP experience reduction in number of lesions and faster resolution after UV light exposure, but relapses are very common. Moreover, uncontrolled UV-light exposure will increase the risk for development of melanoma and nonmelanoma skin cancer.
Chemotherapy
MTX is the most widely used single-agent chemotherapy to treat LYP patients with a total of 79 reported patients.61,72-81 MTX was mostly used in a low-dose scheme (ie, ≤ 25 mg given at 1- to 4-week intervals).78 In the largest retrospective study, including 40 patients with LYP, 44% of the patients did not develop new lesions and 42% of patients had only few new lesions during therapy with 15-25 mg MTX subcutaneous weekly.78 After discontinuation of treatment, no relapse was observed in 10 of 40 patients (25%) during the follow-up period of 24 to 227 months. Side effects were reported in 77% of patients, including hepatic fibrosis in 5 of 10 patients treated with MTX for more than 3 years. In summary, MTX is effective in controlling the disease, but rapid relapse of lesions off drug in the majority of patients (47 of 75 patients; 63%) required maintenance therapy over several months or years.74,76-78 Topical nitrogen mustard (aqueous solution or ointment-based vehicle), used frequently in MF, was reported to induce a sustained remission in only one of the 17 patients with LYP (6%).72,78,82 Topical BCNU (carmustine), a nitrosurea compound, was effective in suppressing disease activity in LYP with rapid reduction in the number, size, and life cycle time of lesions in 8 of 9 patients but without sustained remission.13,78 A variety of multiagent chemotherapeutic regimens are able to induce regression of LYP lesions, but almost all patients had relapses shortly after withdrawal.4,8,10,11,15,66,83
Corticosteroids
In daily practice, topical steroids are probably most often used for initial treatment. Treatment with topical steroids has been documented in detail in 25 patients with CR observed in only 3 of 25 patients (12%).63,72,84-90 Topical steroids are often combined with other therapies, such as antibiotics or phototherapy.72 In one study of children with LYP, with halobetasol or clobetasol propionate applied twice per day for 2 to 3 weeks followed by weekly pulsed application, complete resolution of all lesions occurred over 6 months, but 2 of the 3 children developed new lesions.87 In summary, topical steroids alone or in combination with other therapies may hasten regression of lesions, but they do not prevent occurrence of new lesions. The reported data do not allow assessing effectiveness of topical steroids in LYP.72 Oral corticosteroids were ineffective in all 5 patients reported in the literature.84
Immunomodulatory therapy and retinoids
There are only very limited data on other therapies such as IFN-α, retinoids, bexarotene, and imiquimod in LYP.76,80,88,91-95 CR was observed in 4 of 5 patients after 2-6 weeks of treatment with 3-15 MU IFN-α per week in an open trial.94 Discontinuation resulted in relapses within 3-4 weeks and the necessity for maintenance therapy over 10-17 months.94 Recent experimental data suggest that combined use of MTX and IFN-α could be useful in LYP.96 Despite that expression of Toll-like receptors has been demonstrated in CD30+ LPDs, the Toll-like receptor agonist imiquimod was reported only in 1 patient with CR, in whom all treated lesions resolved within 2 weeks.80,97 CR was observed in one of 3 patients treated with oral bexarotene (150-650 mg, orally daily) in a prospective, uncontrolled, nonrandomized study.95 Topical bexarotene resulted in CR in only one patient after 13 months and PR in 4 of 7 patients without data on follow-up.95
Radiotherapy has been used with various techniques and protocols.10,12,15,77,84,85,98,99 Controversial results were seen with Grenz ray irradiation, which resulted in complete regression of treated lesions in 6 patients77 but had no effect in another series of 3 patients.98 Both Grenz ray treatment and orthovoltage therapy were followed by relapses.10,84,85,99 One patient treated by electron beam irradiation experienced CR.12
Other treatments
Table 7 lists other therapeutic approaches, for which only a very limited number of patients have been reported or detailed data on response, relapse, or outcome are lacking.
Noninterventional strategy (“wait-and-see strategy”)
Observation of natural disease course appears as a legitimate approach in LYP considering the excellent prognosis of LYP and the high recurrence rate after almost all therapies. Detailed data were reported for 5 adults and 11 children.6,8,10,60,67,71,72,86,98-100 In 10 of 11 children, there was ongoing disease and CR was observed in only one child.71,99 CR was reported in 5 adults, but no details on the length of disease course were available. None of the patients who were not treated developed second lymphoid neoplasms.
Recommendations
Because none of the therapies for LYP has been proven to alter the course of the disease and to prevent LYP-associated second lymphomas, abstention from active therapeutic intervention is a legitimate first-line approach, especially in patients with a limited number of lesions (Table 5). For patients with numerous, disseminated, or stigmatizing lesions, phototherapy, in particular PUVA, and low-dose MTX are the best documented therapies for LYP. Various schemes for dosage (mostly low-dose, ie, 5-30 mg/week), application form (orally, subcutaneously, intramuscularly) and duration of treatment (weeks to years; with or without therapy-free intervals) are used to treat patients with LYP. Both, PUVA and MTX show high response rates with reduction and faster healing of lesions in the majority of patients, but sustained CR with regression of all lesions is only rarely achieved. Relapse occurs rapidly within several weeks after dose reduction or withdrawal of treatment with recurrence rates of at least 40%. Similar results have been described for other therapeutic approaches evaluated on smaller series of patients, including interferons, retinoids, and antibiotics, but the evidence for those therapies is too low to recommend as first-line therapy. Because of the high proclivity of LYP to relapse, maintenance treatment may be required to control the disease but may be followed by long-term complications, such as the higher incidence of nonmelanoma skin cancer in patients treated with PUVA or development of hepatic fibrosis after long-term use of MTX, which requires monitoring of therapy.38 For larger LYP lesions (arbitrarily defined as > 2 cm in diameter), which can persist for months, SE or RT is recommended as an alternative approach to a wait for spontaneous regression. In larger lesions or any lesion without spontaneous regression after months, however, progression to PCALCL should be considered.
Multiagent chemotherapy often leads to reduction or clearance of LYP lesions, but rapid recurrence of LYP shortly after or even during treatment is a consistent finding. Multiagent chemotherapy should therefore be avoided both because of its ineffectiveness and because of the side effects and long-term complications. LYP patients should be followed life-long because of the risk for second lymphoid neoplasms, which is reported to occur in 4%-25% of patients and may arise even decades after the manifestation of LYP and in the absence of LYP lesions. In this context, LYP is most commonly associated with MF.
Conclusion
The presented recommendations for the management of CD30+ LPDs are based on the data from small cohort series and case reports as well as the institutional experience of the members of the EORTC Cutaneous Lymphoma Task Force, ISCL, and USCLC. Despite more than 100 studies with therapeutic data on LYP and PCALCL that have been published, only a subset provides detailed information on the response to initial treatment, relapse rate, and outcome or long-term follow-up.
For PCALCL, SE and RT are recommended first-line therapies for solitary or grouped lesions. Multiagent chemotherapy is only indicated for extracutaneous tumor spread beyond locoregional lymph nodes. The best treatment for multifocal PCALCL has still to be determined because so far only anecdotal data for the previously reported therapeutic approaches have been reported. Prospective therapeutic studies are needed to clarify which therapy is most effective for multifocal and for relapsing PCALCL. Multiagent chemotherapy is only indicated for extracutaneous spread.
None of the available therapies for LYP appears unequivocally effective in preventing LYP-associated second lymphomas, although this point has not been systematically addressed in prospective studies. Therefore, abstention from active therapeutic intervention is a legitimate first-line approach in LYP. For patients requiring treatment, potential side effects, long-term complications, and costs of any therapeutic intervention have to be balanced against the favorable prognosis and outcome in most patients with CD30+ LPD, respecting the concept of primum nil nocere.
One major limitation in assessing the effectiveness of therapeutic approaches in CD30+ lymphomas relates to the proclivity of skin lesions in LYP and also in PCALCL for spontaneous regression. Therefore, the impact of any form of active treatment has always to be weighed against the possibility of spontaneous resolution. The regression of individual lesions in LYP cannot be assigned to a direct effect of treatment because spontaneous regression is the characteristic clinical feature and a diagnostic criterion for LYP. Relevant endpoints for therapeutic trials in LYP are CR defined as cessation of the disease (ie, absence of any new lesions). Therefore, we propose definitions for future studies in patients with CD30+ LPDs to enable documentation of efficacy and better comparability of data (Tables 8 and 9). These definitions represent a modification of the recently reported clinical endpoints and response criteria in MF and Sézary syndrome.101 They include counting the number of LYP lesions before, during, and after therapeutic intervention for an objective documentation of tumor burden and response to treatment. Increased disease activity has been introduced as a new term to describe an increase of papulonodular lesions of > 50% above baseline in patients with LYP during treatment. In contrast to progressive disease, defined as occurrence of large (> 2cm) and persistent nodules or extracutaneous spread of disease, increased disease activity has no prognostic implication because the mere number of papulonodular skin lesions in LYP is not linked to prognosis but rather reflects extent and activity of disease.
Because of overlapping histologic and phenotypic features of CD30+ LPDs, the final diagnosis has to be based on a synthesis of clinical, histologic, phenotypic, and molecular genetic findings. Because diagnostic workup requires a close collaboration between clinicians and dermatopathologists or pathologists, patients with CD30+ LPDs should best be managed in centers specialized for cutaneous lymphomas. In regard to the lack of evidence for all reported therapies, prospective controlled and randomized trials are urgently needed to evaluate the effect of therapeutic interventions in CD30+ LPDs.
The publication costs of this article were defrayed in part by page charge payment. Therefore, and solely to indicate this fact, this article is hereby marked “advertisement” in accordance with 18 USC section 1734.
Authorship
Contribution: W.K., M.H.V., and R.W. conceived and designed the study, analyzed and interpreted the data, and supervised the study; W.K., K.P., and A.C. acquired the data; W.K., M.H.V., and E.O. drafted the manuscript; W.K., K.P., S.O.-M. performed statistical analysis; and all authors critically revised the manuscript for important intellectual content.
Conflict-of-interest disclosure: M.B. and B.D. are members of the French scientific board of Cephalon. M.D. is a starting investigator initiated in trial of SGN35 with Seattle genetics. S.H. received research funds and has consulted for Seattle Genetics, Allos, Celgene, and Merck. Y.H.K. has consulted for Seattle Genetics, Allos, and Millennium. H.M.P. is on the advisory boards for Celgene and Merck. S.W. is on the advisory boards for Roche and Novartis. The remaining authors declare no competing financial interests.
Correspondence: Werner Kempf, Department of Dermatology, Cutaneous Lymphoma Study Group, University Hospital Zürich, Gloriastrasse 31, CH-8091 Zürich, Switzerland; e-mail werner.kempf@access.uzh.ch.
References
Author notes
The groups involved in the consensus recommendations are as follows: European Organization for Research and Treatment of Cancer (EORTC), International Society of Cutaneous Lymphoma (ISCL), and United States Cutaneous Lymphoma Consortium (USCLC).
K.P. and M.H.V. contributed equally to this study.